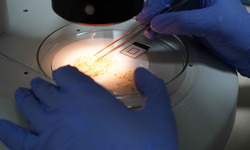
Mikroplastik tehlikesi hayatı tehdit ediyor

mikroplastik
mikroplastik haberleri
mikroplastik haberleri ve güncel mikroplastik gelişmeleri, mikroplastik ile ilgili tüm video, mikroplastik fotoğrafları ve mikroplastik haberleri Antalya Ekspres sitemizde
AKDENİZ Üniversitesi'nden Doç. Dr. Olgaç Güven, denizlerdeki plastik kirliliği ve mikroplastik tehdidine karşı uyarıda bulundu. Kirliliğin sadece çevresel değil, sosyoekonomik...